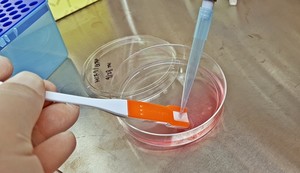
30초만에 세포 분리 마치고 "커피 한잔?" - 뉴스 썸네일 이미지

| 임원 | 최초 등기 | 최근 등기 | 전체 등기 소속 |
|---|---|---|---|
 한국∙만 ??세 | 사내이사 2025-12-24 |  페라메드 사내이사 |
기업 개요
 홈페이지
홈페이지 주식회사 페라메드(Ferramed)는 2014년 3월에 설립된 한국계∙스타트업입니다.
바이오/의료∙연구/실험 분야의 셀 트래퍼가 주요 제품/서비스입니다.
2023년 대체육, 배양육, 곤충지방 관련 국가 R&D를 수행했습니다.
본사는 한국∙대전광역시에 위치해있습니다. 현재 대표자는 김세일입니다.
유사 기업은 비에스엘레스트∙엠크래프츠∙레보스케치∙한일과학산업 등이 있습니다.
제품/서비스
총 1개최근 뉴스
- ·기타대전시, 민간 투자 유치 활성화 '바이오테크코리아' 개최

- ·기타설쌤과 '펫 콘서트', 벤처·창업기업 바이어 상담회 등 다채

- ·파트너십"산학연병 협업해 '대전 바이오 생태계 구축'...투자 유치 박차"

- ·기타대전시, 2023년 제1회 바이오테크코리아 개최

재무 상세
재무제표
| 계정 과목 | 202212월 · 개별 | 202312월 · 개별 | 202412월 · 개별 | 전기 대비 증감 (2024) | 추세 |
|---|---|---|---|---|---|
유동자산 | 프로 플랜 필요 | 프로 플랜 필요 | 프로 플랜 필요 | 프로 플랜 필요 | 프로 플랜 필요 |
비유동자산 | 프로 플랜 필요 | 프로 플랜 필요 | 프로 플랜 필요 | 프로 플랜 필요 | 프로 플랜 필요 |
자산총계 | 프로 플랜 필요 | 프로 플랜 필요 | 프로 플랜 필요 | 프로 플랜 필요 | 프로 플랜 필요 |
유동부채 | 프로 플랜 필요 | 프로 플랜 필요 | 프로 플랜 필요 | 프로 플랜 필요 | 프로 플랜 필요 |
비유동부채 | 프로 플랜 필요 | 프로 플랜 필요 | 프로 플랜 필요 | 프로 플랜 필요 | 프로 플랜 필요 |
부채총계 | 프로 플랜 필요 | 프로 플랜 필요 | 프로 플랜 필요 | 프로 플랜 필요 | 프로 플랜 필요 |
자본금 | 프로 플랜 필요 | 프로 플랜 필요 | 프로 플랜 필요 | 프로 플랜 필요 | 프로 플랜 필요 |
당기순손익 | 프로 플랜 필요 | 프로 플랜 필요 | 프로 플랜 필요 | 프로 플랜 필요 | 프로 플랜 필요 |
자본총계 | 프로 플랜 필요 | 프로 플랜 필요 | 프로 플랜 필요 | 프로 플랜 필요 | 프로 플랜 필요 |
부채및자본총계 | 프로 플랜 필요 | 프로 플랜 필요 | 프로 플랜 필요 | 프로 플랜 필요 | 프로 플랜 필요 |
- 상세 재무 데이터는 원본 자료를 기반으로 최대한 충실히 반영하였으나, 정확성·완전성·최신성 및 적시성을 보장하지 않으며, 이에 따른 오류·누락·지연 또는 해석상의 차이로 발생하는 손해에 대해 당사는 법적 책임을 지지 않습니다.
- 재무 데이터 출처: 금융감독원, 중소벤처기업부.
- 1

- 2

- 3

- 1

- 2

- 3

- 1

- 2

- 3

* R&D 타임라인은 통합 과제 중 종료일 기준으로 최신 과제 일부만을 표시합니다.
* 과거 회사명부터 지금 회사명까지의 인원 변동을 확인할 수 있습니다.
* 본점, 지점의 고용 데이터를 합산하여 산출한 결과입니다.
| 회사 | 제품/서비스 | 기술 | 분야 | 투자 유치 | |
|---|---|---|---|---|---|
현재  페라메드 한국∙스타트업 |  셀 트래퍼 세포 분리 기구 | 제조 | 바이오/의료 연구/실험 | 알 수 없음 알 수 없음 | |
 지방줄기세포 자동분리기 세포치료를 위한 SVF 자동분리기 | 제조 | 바이오/의료 연구/실험 | 알 수 없음 알 수 없음 | ||
 주사전자현미경 나노기술 연구장비 | 제조 | 바이오/의료 연구/실험 | Series A 88억원 | ||
 디지쿽 초고감도 디지털 PCR | 제조 | 바이오/의료 연구/실험 | Series B 29억 9990만원 | ||
 마이크로 원심분리기 냉장 마이크로 원심분리기 | 제조 | 바이오/의료 연구/실험 | 알 수 없음 알 수 없음 | ||
 100% 자동화 엑소좀 분리기기 렙온어칩을 활용한 순도 높은 엑소좀의 효율적인 분리기술을 바탕으로 액체생검을 위한 100% 자동 엑소좀 분리기기 | 연구개발 | 바이오/의료 연구/실험 | Seed 2억원 | ||
 비타릭스 세포의 적층 성형이 가능한 3D 바이오 프린터 | 3D프린터 | 바이오/의료 연구/실험 | Series A 105억원 |
| 구분 | 페라메드 | 비에스엘레스트 | 엠크래프츠 | 레보스케치 |
|---|---|---|---|---|
| 제품/서비스 |
|
|
|
|
| 국적 | 한국 | 한국 | 한국 | 한국 |
| 분류 | 스타트업 | 스타트업 | 중소기업 | 스타트업 |
| 본사 소재지 | 한국 > 대전광역시 | 한국 > 경상남도 > 김해시 | 한국 > 경기도 > 하남시 | 한국 > 대전광역시 |
| 분야 | 바이오/의료 1 | 바이오/의료 1 | 바이오/의료 1 | 바이오/의료 1 |
| 기술 | 제조 1 | 제조 1 | 제조 1 | 제조 1 |
| 업력 | 12.3년 | 7년 | 14.8년 | 9.5년 |
| 매출 | ||||
| 임직원수 | 4명2025년 12월 | 알 수 없음 | 19명2026년 4월 | 14명2026년 4월 |
| 누적 투자 유치액 | 알 수 없음 | 알 수 없음 | ||
| 최근 투자 라운드 | 해당 없음 | 해당 없음 | Series A | Series B |
| 최근 투자 유치일 | 해당 없음 | 해당 없음 | ||
FI 투자자 (누적 집행금액순) | 해당 없음 | 해당 없음 | 5개사 | 2개사 |
SI 투자자 (누적 집행금액순) | 해당 없음 | 해당 없음 | 해당 없음 | 2개사 |
해외 투자자 (누적 집행금액순) | 해당 없음 | 해당 없음 | 해당 없음 | 해당 없음 |
















 신소재경제신문
신소재경제신문